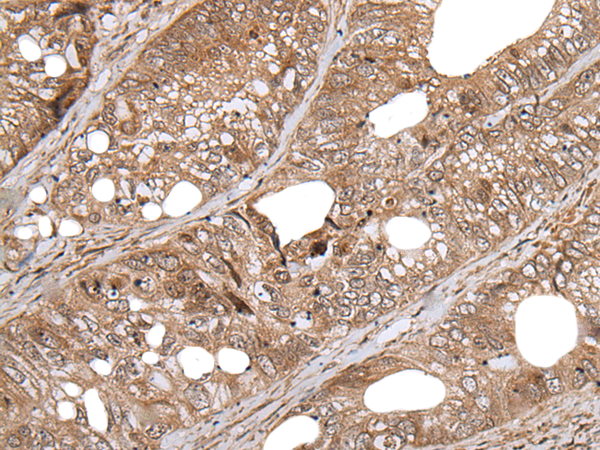

-
分类: 科研抗体货号: P12976别名: PIBF; CEP90; C13orf24应用: WB,IHC反应种属: Human
-
分类: 科研抗体货号: P12955别名: CV2; CV-2; CRIM3应用: IHC反应种属: Human, Mouse
-
分类: 科研抗体货号: P12975别名: APC15; HSPC020; C11orf51应用: IHC反应种属: Human, Mouse, Rat
-
分类: 科研抗体货号: P12953别名:应用: WB,IHC反应种属: Human, Mouse, Rat
-
分类: 科研抗体货号: P12974别名: D123; C10orf7应用: IHC反应种属: Human, Mouse, Rat
-
分类: 科研抗体货号: P12952别名: PCP; TLD; OI13; PCP2; PCOLC应用: IHC反应种属: Human, Mouse
-
分类: 科研抗体货号: P12973别名: CFAP106; C10orf63应用: IHC反应种属: Human
-
分类: 科研抗体货号: P12951别名: FLR; BVRB; SDR43U1; HEL-S-10应用: WB,IHC反应种属: Human, Mouse
-
分类: 科研抗体货号: P12972别名: C10orf57; bA369J21.6应用: WB反应种属: Human, Mouse
-
分类: 科研抗体货号: P12950别名: BS; RECQ2; RECQL2; RECQL3应用: IHC反应种属: Human

鄂公网安备42018502007531号
鄂公网安备42018502007531号

